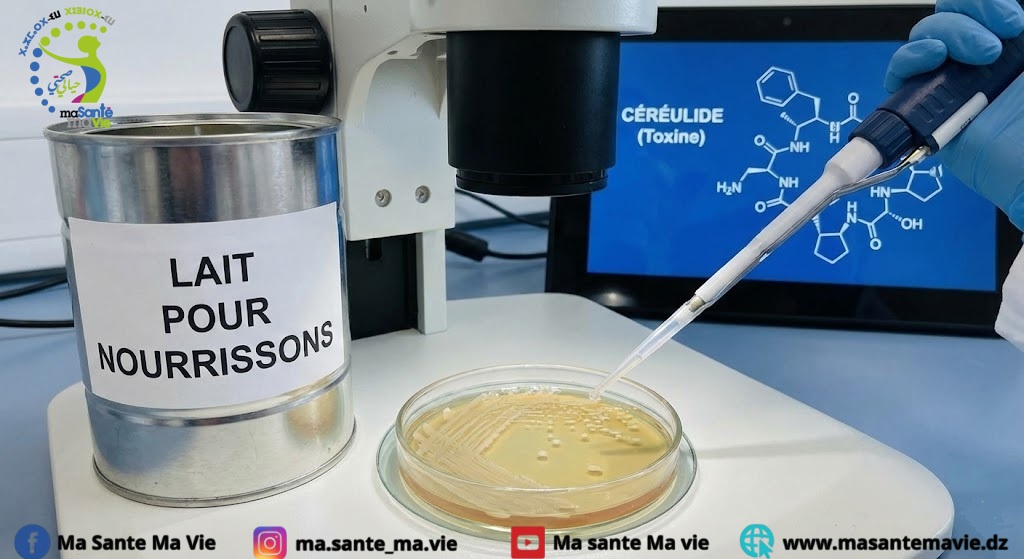

Un rappel sanitaire d’ampleur concerne depuis début janvier 2026 plusieurs laits infantiles commercialisés par le groupe Nestlé, notamment sous les marques Guigoz et Nidal. Cette mesure préventive, mise en place en France et dans plusieurs pays européens, fait suite à la détection d’un incident de qualité impliquant un ingrédient susceptible de contenir une toxine bactérienne rare mais potentiellement dangereuse : le céréulide.
Alors que des investigations sont toujours en cours, le signalement du décès d’un nourrisson ayant consommé l’un des laits concernés a ravivé l’inquiétude des familles.
Que s’est-il passé ?
Selon les informations révélées par Radio France, un nourrisson est décédé après avoir consommé du lait Guigoz issu de lots rappelés. Le ministère de la Santé a confirmé l’ouverture d’une enquête afin d’analyser le produit et d’évaluer un éventuel lien avec la toxine suspectée.
À ce stade, aucun lien de causalité formel n’a été établi entre le décès et la consommation du lait. Les résultats des analyses sont attendus dans les prochains jours.
Nestlé affirme avoir déclenché ce rappel de manière volontaire et par précaution, en coordination avec les autorités sanitaires, dès que la traçabilité des lots concernés a été confirmée.
Une alerte remontée par plusieurs familles
Outre ce décès, plusieurs dizaines de familles ont signalé des troubles digestifs chez leurs nourrissons après consommation des laits concernés. Selon Radio France :
- Environ 60 appels ont été recensés par les centres antipoison
- Plusieurs signalements ont été adressés aux Agences régionales de santé (ARS)
- Certains nourrissons ont nécessité une prise en charge médicale
Dans la majorité des cas, les parents ont cessé immédiatement l’utilisation du lait après avoir pris connaissance du rappel.
Le céréulide : une toxine rare mais redoutable
La substance mise en cause, le céréulide, est une toxine produite par certaines souches de la bactérie Bacillus cereus. Elle est particulièrement redoutée car :
- Elle résiste aux traitements thermiques classiques
- Elle peut persister malgré la cuisson ou la stérilisation
- Elle agit rapidement après ingestion
Quels symptômes peut-elle provoquer ?
Dans la majorité des situations, le céréulide entraîne des troubles digestifs bénins et transitoires :
- Vomissements répétés
- Diarrhées
- Douleurs abdominales
- Refus de s’alimenter
Ces symptômes apparaissent généralement entre 30 minutes et 6 heures après l’ingestion.
Chez les nourrissons : des risques accrus
Chez les très jeunes enfants, le risque principal est la déshydratation rapide, liée aux vomissements et aux diarrhées. Plus rarement, des formes graves ont été décrites par l’Anses :
- Septicémie
- Entérocolite nécrosante
- Hépatite fulminante
- Encéphalopathie
- Abcès cérébral
Ces complications restent exceptionnelles, mais justifient une vigilance renforcée.

Quels signes doivent alerter immédiatement ?
Les autorités sanitaires et les pédiatres recommandent de consulter en urgence si un nourrisson présente :
- Des vomissements répétés ou incoercibles
- Une diarrhée abondante
- Une fièvre inhabituelle
- Une somnolence excessive ou une grande irritabilité
- Une diminution des urines (moins de couches mouillées)
- Un teint pâle ou grisâtre
- Un refus persistant de s’alimenter
Chez le nourrisson, tout trouble digestif important doit être évalué rapidement, quelle qu’en soit la cause.
Que doivent faire les parents ?
Les recommandations officielles sont claires :
- Vérifier immédiatement les références et numéros de lots sur les emballages
- Ne pas utiliser les produits concernés par le rappel
- Rapporter les laits rappelés au point de vente
- Contacter un professionnel de santé au moindre doute
En l’absence de symptômes, aucun impact à long terme n’est attendu, selon Nestlé.
Un message de prudence, sans panique
Les spécialistes rappellent que les troubles digestifs sont fréquents chez les nourrissons en période hivernale et qu’ils ne sont pas systématiquement liés à une intoxication alimentaire.
Les investigations se poursuivent afin de déterminer précisément les responsabilités et les mécanismes en cause. De nouvelles informations seront communiquées au fur et à mesure de l’avancée des analyses.
En attendant, la vigilance, la vérification des lots et une consultation médicale rapide en cas de symptômes restent les meilleures mesures de protection pour les nourrissons.
Mots clés : lait ; enfant ; bébé ; malade ; décès ; céréulide ; vomissement ; toxine ;
à lire aussi: